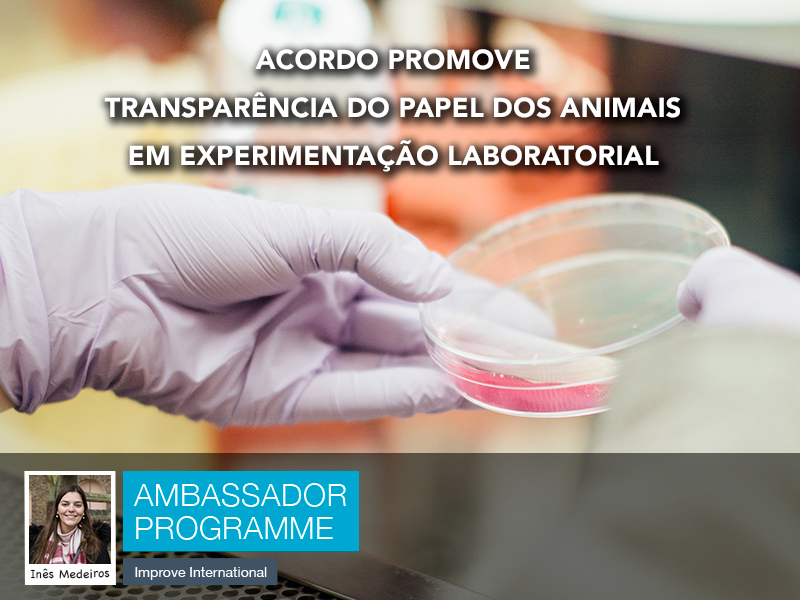

Acordo promove transparência no papel dos animais em experimentação laboratorial
Em Braga, dia 20 de Julho, é lançado acordo que conta com a assinatura de 16 instituições científicas portuguesas, de forma a clarificar até que ponto os animais podem ser utilizados em atividades e experimentação laboratorial em Portugal. O maior objetivo é demonstrar e clarificar qual é a utilização de animais neste campo. O acordo foi lançado durante o IV Congresso da Sociedade Portuguesa de Ciências em Animais de Laboratório (SPCAL). Denomina-se de Acordo de Transparência sobre a Investigação Animal em Portugal. Por ser um tema sensível, este tipo de experimentação sempre foi feita com certas reservas, não tendo grande divulgação. Agora, devido às alterações recentes em termos de leis que atuam em animais e à consciencialização da sociedade portuguesa é necessário responder a questões levantadas e tranquilizar a população. Neste sentido, pretende-se transmitir que há uma necessidade de utilizar animais em investigação para benefício humano, mas é possível fazer o mesmo sem desrespeitar o bem-estar animal, respeitando a ética e cumprindo regulamentos.
As empresas que assinaram o acordo precisam de cumprir cinco estratégias de transparência. Primeiro, têm de colocar uma declaração no seu site referente ao bem-estar animal e um link para o acordo de transparência. Depois, terão de dar ao público informação que seja pertinente sobre as condições em que é feita a investigação animal e os resultados que obtém das mesmas. Por fim, terão de promover iniciativas que promovam conhecimento e compreensão da população sobre a experimentação animal, quais os seus objetivos, os seus fins e como quais foram os resultados obtidos bem como demonstrar a utilidade dos animais nos estudos nos quais foram utilizados, para que as pessoas entendam a necessidade da utilização de animais nos avanços da medicina.
Apesar de atualmente existirem outros modelos que possam substituir o modelo animal, tais como modelos matemáticos, culturas de células, culturas de tecidos ou órgãos, não substituem o modelo animal para experimentação e desenvolvimento de alguns tipos de fármacos e vacinas.
